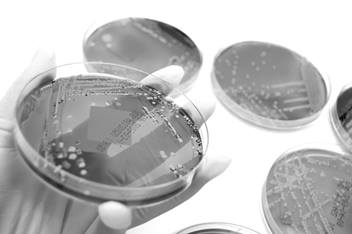

Kapoor Lab
Many important human viruses lack appropriate animal models, restricting studies of viral pathogenesis and immunity. For such human viruses, like Human immunodeficiency virus or human norovirus, their animal homologs proved extremely useful for defining virus-host interactions, immunity and pathogenesis. Our group is characterizing several newly identified rodent viruses to develop informative surrogate models for their human homologs.
Despite the availability of effective antivirals, chronic HCV infection remains a leading cause of liver-specific morbidity and mortality. Mechanisms underlying HCV persistence are poorly understood, and efforts at vaccine development have been stymied by the lack of an appropriate small animal model. We developed the first fully immunocompetent surrogate models to study hepacivirus immunity and pathogenesis. Our current studies are focused on using rodent hepacivirus model to define the immunopathogenesis of Hepatitis C virus (HCV). A sister project in our lab focuses on the development of T and B cell vaccines to define the nature and breadth of immunity required for protection against homologous and heterologous HCV-like viruses. In addition to conventional cell phenotyping and functional assays, our lab is routinely using bulk and single cell RNA-seq to gain new insights into the nature of host responses culminating in the clearance and persistence of these viruses in their natural host.
Featured Research Projects
What are the immune correlates of protection against HCV persistence? Can immunity conferred by natural virus clearance or vaccination protect against heterologous viruses? We isolated several strains of HCV-like viruses from feral rats, developed a reverse genetic system for rat hepacivirus and now we’re using these genetically diverse variants to study the nature and breadth of immunity conferred by vaccination or spontaneous virus clearance in laboratory rats and mice. To test vaccine efficacy, we are using laboratory rats, since they are the natural host of these viruses and are therefore fully susceptible to HCV-like lifelong viral persistence seen in humans. Parallel studies in mice are used to accurately define the role of host factors in viral immunity and pathogenesis. We expect our studies will inform the research and development of HCV vaccines for humans.
How do different liver cells respond to HCV infection? What transcriptome changes presage different infection outcomes? What is the origin of liver inflammation during chronic HCV infection? We are optimizing approaches to disintegrate liver into constituent cells, while preserving their transcriptomes for RNA-seq analysis.
GBV-C or Human Pegivirus is a common human infection. The virus is genetically related to HCV and belongs to the family Falviviridae. In developed countries, 1-5%, and in developing countries, up to 20% of healthy blood donors were found positive for GBV-C viremia. GBV-C can establish persistent infection, more commonly in HIV or HCV infected individuals. Similarly, Torque-teno viruses are small-circular DNA viruses that commonly infect humans and are more prevalent in blood transfusion recipients. Both these viruses are common components of human blood virome, are strictly species specific, and thus lack animal models. We recently isolated homologs of these viruses from feral rodents to develop informative laboratory models. Our goal is to determine the health relevance of these viral infections and mechanisms underlying their persistence.
We are characterizing the viromes of feral and wild rodents. Our recent published work describes many new animal viruses, including the first identification of animal HCV-like viruses. More recently, we identified a new parvovirus associated with Theiler’s diseases in horses. We are also characterizing viromes in human clinical samples to understand how virome composition affects human health.